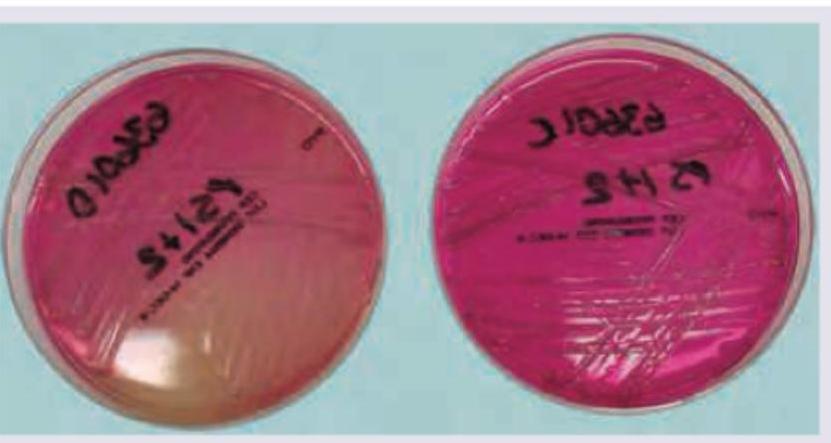
Image for question 2072

Which of the following bacteria has the flagellar characteristic shown in the image?

A 13-year-old girl with cystic fibrosis has been having recurrent severe respiratory infections and transtracheal aspirate was sent for culture. The growth of pink colonies in the image shows presence of:
All are true about Helicobacter pylori on special stain preparation of stomach except:
Which one of the following is the causative organism of Erythrasma, a mild, localized and superficial skin infection?
Gas Gangrene resulting in crepitus in tissues and a sweet smelling brown exudate is caused due to infection by :
Which one of the following statements regarding Gas Gangrene Infection is correct?
Clinical signs and symptoms in tetanus are a result of
Which one of the following organisms is not associated with synergistic gangrene?
Donovan bodies are associated with :
The pathogenic organism responsible for the causation of Donovaniasis is
Explanation: ***Leptospira icterohaemorrhagicae*** - The image displays **endoflagella** (axial filaments) located beneath the **outer membrane**, which is characteristic of **spirochetes**. - *Leptospira icterohaemorrhagicae* is a spirochete and possesses these internal flagella, allowing for its distinctive corkscrew motility. *Helicobacter pylori* - *Helicobacter pylori* is a gram-negative bacterium that typically has **lophotrichous flagella** (multiple flagella at one pole), which are external, not internal. - Its motility is crucial for penetrating the gastric mucus, but it does not utilize endoflagella. *Mycobacterium tuberculosis* - *Mycobacterium tuberculosis* is a non-motile bacterium and **lacks flagella** altogether. - Its cell wall structure, rich in mycolic acid, contributes to its pathogenicity and resistance but not to motility via flagella. *Vibrio cholerae* - *Vibrio cholerae* is a gram-negative bacterium that possesses a **single polar flagellum** (monotrichous), which is external. - This external flagellum is essential for its motility in aquatic environments and in the human intestine.
Explanation: ***Burkholderia cepacia*** - In the context of a **cystic fibrosis** patient with recurrent severe respiratory infections, *Burkholderia cepacia* complex is a significant pathogen of concern, associated with **"cepacia syndrome"** - a fulminant necrotizing pneumonia with high mortality. - *B. cepacia* is characteristically an **oxidase-positive, non-lactose fermenter** that typically produces **pale or colorless colonies** on MacConkey agar, NOT pink colonies. However, some strains of the *B. cepacia* complex can show **variable lactose fermentation** or late weak fermentation, which may account for the pink appearance seen in certain isolates. - The clinical scenario (CF patient + severe respiratory infections) strongly suggests *B. cepacia* despite the atypical colonial morphology, as it is one of the most feared pathogens in CF patients due to its resistance patterns and transmissibility. *Pseudomonas aeruginosa* - *Pseudomonas aeruginosa* is the **most common** pathogen in cystic fibrosis and is a **non-lactose fermenter**, producing **colorless or pale colonies** on MacConkey agar with characteristic metallic sheen or pigment production (pyocyanin/pyoverdin). - While extremely common in CF, it does not produce pink colonies on MacConkey agar, which rules it out based on the image finding. *Haemophilus influenzae* - *Haemophilus influenzae* is a **fastidious organism** requiring **X factor (hemin) and V factor (NAD)**, typically grown on **chocolate agar**. - It **does not grow on MacConkey agar** due to lack of required growth factors and the inhibitory nature of bile salts in the medium. - Cannot be the answer as it would not produce any colonies on this medium. *Pseudomonas fluorescens* - *Pseudomonas fluorescens* is a **non-lactose fermenter** producing **colorless or pale colonies** on MacConkey agar, often with fluorescent pigment production under UV light. - It is an **environmental organism** rarely associated with serious respiratory infections in cystic fibrosis, unlike *P. aeruginosa* or *B. cepacia*. - The colonial morphology (pink colonies) does not match this organism.
Explanation: ***S shaped non-flagellated bacteria*** - *H. pylori* are generally **spiral-shaped** or **curved rods**, not typically S-shaped, and are characterized by their **polar flagella** which are essential for their motility in the viscous gastric mucus. - The presence of flagella is a key feature distinguishing *H. pylori* and enabling its survival in the stomach environment. *Steiner stain preparation* - The **Steiner silver stain** is commonly used to visualize *H. pylori* in gastric biopsies, demonstrating them as dark, helical organisms. - While effective, other stains like Giemsa or Warthin-Starry are also used, but Steiner stain is a valid method for detection. *Dormant stage is coccoid form* - Under stressful conditions, such as antibiotic exposure or prolonged culture, *H. pylori* can transform into a **coccoid form**. - This coccoid form is considered a **viable but non-culturable** dormant stage, potentially contributing to persistence and recurrence of infection. *Attaches but does not invade the cells* - *H. pylori* colonizes the **mucus layer** and attaches to the apical surface of gastric epithelial cells but generally **does not invade** the cells. - Its effects are mediated by toxins and enzymes released into the extracellular space, leading to inflammation and cellular damage without direct intracellular invasion.
Explanation: ***Corynebacterium minutissimum*** - This bacterium is the **primary causative agent** of erythrasma, a superficial skin infection. - It produces **porphyrins**, which fluoresce with a characteristic **coral-red color** under a Wood's lamp, aiding in diagnosis. *Corynebacterium matruchotii* - This species is typically found in the **oral cavity** and is associated with dental plaque and periodontal diseases. - It is **not known** to cause erythrasma or superficial skin infections. *Corynebacterium pseudotuberculosis* - This bacterium is a significant pathogen in **animals**, particularly livestock, causing conditions like caseous lymphadenitis. - While it can *rarely* cause infections in humans (e.g., lymphadenitis), it is **not associated** with erythrasma. *Corynebacterium diphtheriae* - This is the causative agent of **diphtheria**, a severe respiratory illness characterized by a pseudomembrane in the throat. - It causes systemic toxemia and is **not responsible** for localized, superficial skin infections like erythrasma.
Explanation: ***Clostridium perfringens*** - **Gas gangrene** is caused by obligate anaerobic, gram-positive rods, notably **Clostridium perfringens**. - This bacterium produces **alpha-toxin (lecithinase)**, which destroys tissues and leads to gas formation (crepitus) and a characteristic **sweet-smelling brown exudate**. *Synergistic bacteria* - While synergistic infections can occur and lead to severe tissue damage, they are not the primary or specific cause of **gas gangrene** with its distinct clinical presentation. - The classic features of gas production and a specific exudate are directly tied to the metabolic activity and toxins of **Clostridial species**. *Anaerobic bacteroides spp.* - **Bacteroides** are common anaerobic bacteria, but they are typically associated with **intra-abdominal abscesses** and **wound infections**, not the specific clinical syndrome of gas gangrene. - They do not produce the potent toxins that lead to extensive gas formation and rapid tissue necrosis characteristic of **Clostridium perfringens**. *Gas-forming Klebsiella spp.* - **Klebsiella spp.** are gram-negative, facultative anaerobic bacteria that can produce gas, especially in deep-seated infections like **emphysematous pyelonephritis** or **liver abscesses**. - However, they do not cause **gas gangrene** with its rapid tissue destruction, crepitus, and sweet-smelling brown exudate, which is pathognomonic for **Clostridial infection**.
Explanation: ***It is caused by C. perfringens, a gram positive anaerobic spore-forming bacilli.*** - **Gas gangrene** is primarily caused by **Clostridium perfringens**, which is a **gram-positive**, **anaerobic**, and **spore-forming bacillus**. - These characteristics allow it to thrive in low-oxygen environments characteristic of deep wounds and produce toxins that cause tissue necrosis and gas formation. *It is caused by C. perfringens, a gram negative aerobic non-spore-forming bacilli.* - This statement is incorrect because **C. perfringens** is a **gram-positive** bacterium, not gram-negative. - Furthermore, it is an **anaerobic** organism, meaning it grows in the absence of oxygen, not aerobic. *It is caused by C. tetani, a gram negative anaerobic non-spore-forming bacilli.* - This statement is incorrect because **gas gangrene** is caused by **C. perfringens**, not C. tetani (which causes tetanus). - Also, **C. tetani** is a **gram-positive** bacterium, not gram-negative, and it is **spore-forming**. *It is caused by C. tetani, a gram positive anaerobic spore-forming bacilli.* - This statement is incorrect because, as mentioned, **gas gangrene** is caused by **C. perfringens**, not **C. tetani**. - While **C. tetani** is indeed **gram-positive**, **anaerobic**, and **spore-forming**, it is the causative agent of **tetanus**, not gas gangrene.
Explanation: ***Exotoxins fixed to nerve endings*** - Tetanus symptoms are caused by **tetanospasmin**, an exotoxin produced by *Clostridium tetani*, which undergoes **retrograde axonal transport** from peripheral nerve terminals to the CNS. - The toxin **irreversibly binds** to presynaptic terminals of **inhibitory interneurons** (Renshaw cells) in the spinal cord, blocking the release of **glycine and GABA**. - This results in **unopposed excitatory impulses** to motor neurons, causing **spastic paralysis** and characteristic muscle rigidity. *Circulating exotoxins* - While tetanospasmin circulates after production at the wound site, it must **bind to nerve tissue** and reach the CNS to exert its pathogenic effects. - Systemic circulation acts as a transport mechanism; the clinical manifestations result from toxin **fixation at neural synapses**, not from circulating toxin. *Endotoxins* - **Endotoxins** are lipopolysaccharides (LPS) found in the outer membrane of gram-negative bacteria. - *Clostridium tetani* is a **gram-positive, spore-forming anaerobic bacillus** that does not produce endotoxins. - Endotoxins play no role in tetanus pathogenesis. *Both endotoxins and exotoxins* - This option is incorrect because *Clostridium tetani* does **not produce endotoxins**. - The clinical manifestations of tetanus are **exclusively due to tetanospasmin**, an exotoxin that acts by blocking inhibitory neurotransmission in the CNS.
Explanation: ***Escherichia*** - ***Escherichia coli* is NOT associated with classic synergistic gangrene** (Meleney's gangrene). - While *E. coli* causes many infections (UTIs, peritonitis, wound infections), it is **not a typical organism** in the polymicrobial synergistic gangrene described by Meleney. - Synergistic gangrene specifically involves **aerobic and microaerophilic organisms** working in combination, which is not the typical pattern for *E. coli* infections. *Staphylococcus* - ***Staphylococcus aureus* is a classic component of synergistic gangrene** (Meleney's gangrene). - Typically works in synergy with **microaerophilic streptococci** to cause progressive necrotizing infection. - *S. aureus* creates conditions that allow **anaerobic and microaerophilic organisms** to proliferate. *Clostridium* - ***Clostridium* species are associated with necrotizing soft tissue infections**, particularly gas gangrene (*C. perfringens*). - While gas gangrene differs from classic Meleney's synergistic gangrene, clostridial infections can occur in **polymicrobial settings** with synergistic tissue destruction. - They produce powerful **exotoxins** (alpha toxin, collagenase) causing rapid necrosis and gas formation. *Peptostreptococcus* - ***Peptostreptococcus* species are frequently isolated from synergistic gangrene**. - These **anaerobic gram-positive cocci** are key components of polymicrobial necrotizing infections. - They create an **anaerobic environment** that promotes tissue necrosis and allows other organisms to thrive.
Explanation: ***Granuloma inguinale*** - **Donovan bodies** are characteristic intracellular inclusions found within macrophages in tissue samples from patients with **granuloma inguinale**, also known as **donovanosis**. - These bodies are the causative organism, *Klebsiella granulomatis*, encapsulated within phagosomes, and appear as safety pin-shaped structures. *Gonorrhoea* - This sexually transmitted infection is caused by **Neisseria gonorrhoeae**, a Gram-negative diplococcus. - Diagnosis is typically based on identifying the organism in smears or cultures, not by Donovan bodies. *Chlamydia trachomatis infection* - **Chlamydia trachomatis** is an obligate intracellular bacterium that causes various infections, including cervicitis, urethritis, and lymphogranuloma venereum. - While it causes inclusion bodies within host cells, these are distinct from Donovan bodies and are known as **chlamydial inclusion bodies**. *Herpes genitalis* - This is a viral infection caused by the **herpes simplex virus (HSV)** type 1 or 2. - Diagnosis involves viral culture, PCR, or the identification of **Tzanck cells** (multinucleated giant cells) in vesicular fluid, not Donovan bodies.
Explanation: ***Klebsiella granulomatis*** - This bacterium is the causative agent of **granuloma inguinale**, also known as **donovaniasis**. - It infects macrophages and causes chronic, progressive **genital ulcers** with a characteristic beefy-red appearance. *Herpes simplex virus* - This virus causes **genital herpes**, characterized by painful **vesicular or ulcerative lesions** that tend to recur. *Haemophilus ducreyi* - This bacterium causes **chancroid**, characterized by painful, soft chancres with **ragged, undermined borders**. *Chlamydia trachomatis* - This bacterium is responsible for several sexually transmitted infections, including **lymphogranuloma venereum (LGV)**, which presents with transient genital lesions followed by painful, suppurative lymphadenopathy, and **genital chlamydial infections** which often cause urethritis or cervicitis.
Staphylococci
Practice Questions
Streptococci and Enterococci
Practice Questions
Neisseria and Moraxella
Practice Questions
Corynebacterium and Listeria
Practice Questions
Bacillus and Clostridium
Practice Questions
Enterobacteriaceae
Practice Questions
Vibrio, Aeromonas, and Plesiomonas
Practice Questions
Pseudomonas and Related Bacteria
Practice Questions
Haemophilus and HACEK Group
Practice Questions
Bordetella and Brucella
Practice Questions
Mycobacteria
Practice Questions
Spirochetes
Practice Questions
Get full access to all questions, explanations, and performance tracking.
Start For Free